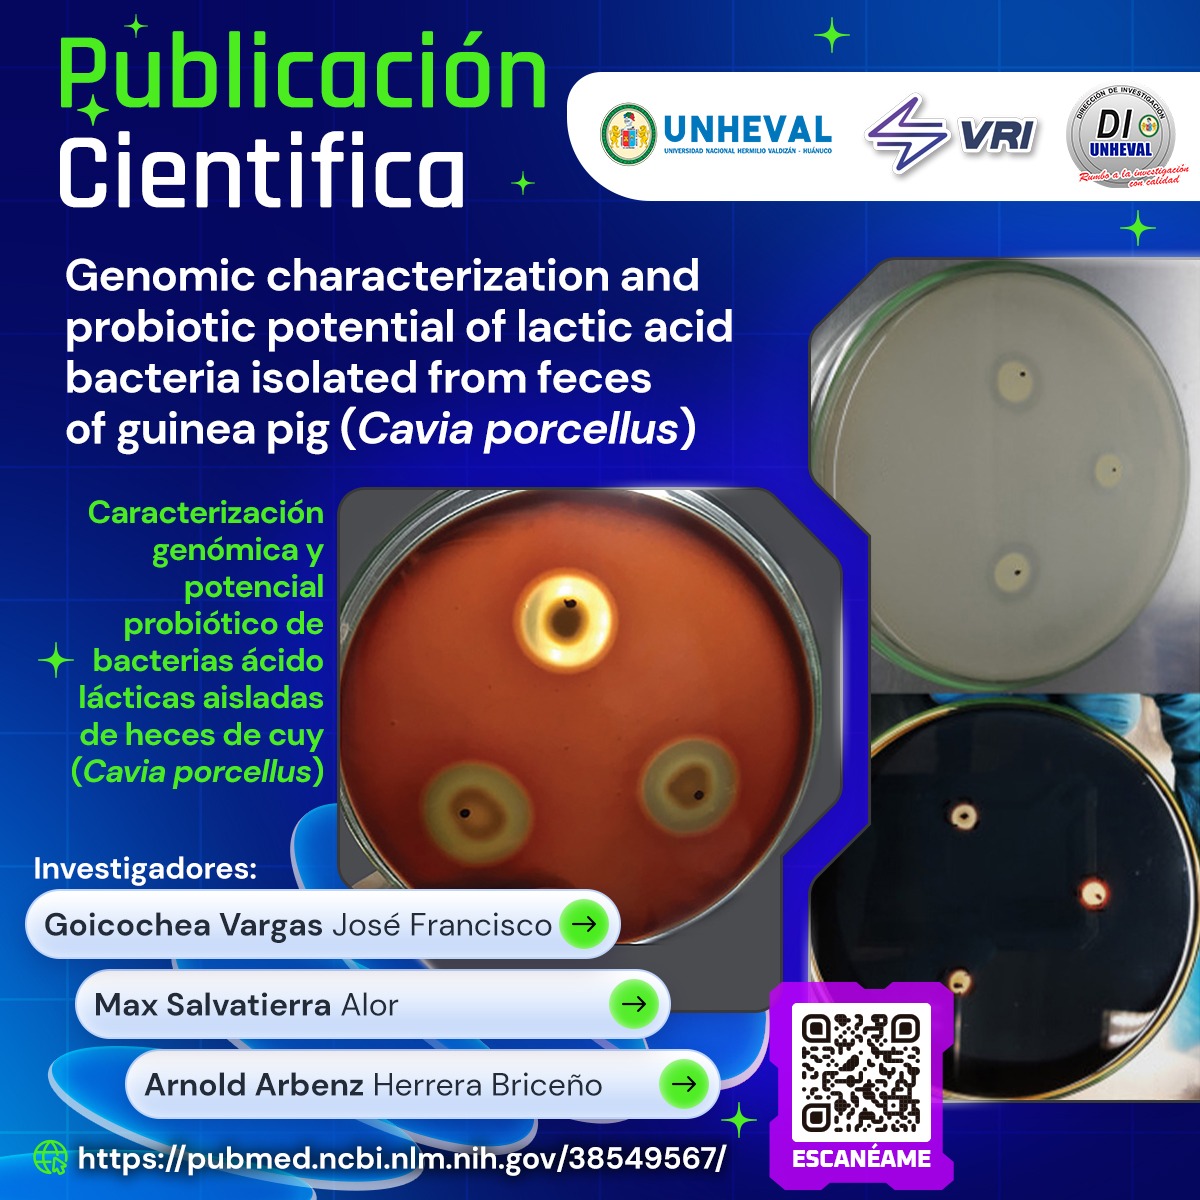

PUBLICACIÓN EN REVISTAS DE ALTO IMPACTO
🧬🔬𝐎𝐫𝐠𝐮𝐥𝐥𝐨 𝐚𝐜𝐚𝐝𝐞́𝐦𝐢𝐜𝐨: 𝐃𝐨𝐜𝐞𝐧𝐭𝐞 𝐈𝐧𝐯𝐞𝐬𝐭𝐢𝐠𝐚𝐝𝐨𝐫 𝐲 𝐬𝐮 𝐞𝐪𝐮𝐢𝐩𝐨 𝐝𝐞 𝐥𝐚 𝐔𝐧𝐢𝐯𝐞𝐫𝐬𝐢𝐝𝐚𝐝 𝐍𝐚𝐜𝐢𝐨𝐧𝐚𝐥 𝐇𝐞𝐫𝐦𝐢𝐥𝐢𝐨 𝐕𝐚𝐥𝐝𝐢𝐳𝐚𝐧 𝐩𝐮𝐛𝐥𝐢𝐜𝐚 𝐞𝐧 𝐫𝐞𝐯𝐢𝐬𝐭𝐚𝐬 𝐝𝐞 𝐚𝐥𝐭𝐨 𝐢𝐦𝐩𝐚𝐜𝐭𝐨🧬🔬
La Dirección de Investigación felicita al Docente Investigador 𝐆𝐨𝐢𝐜𝐨𝐜𝐡𝐞𝐚 𝐕𝐚𝐫𝐠𝐚𝐬 𝐉𝐨𝐬𝐞́ 𝐅𝐫𝐚𝐧𝐜𝐢𝐬𝐜𝐨 y a su equipo de investigación por su destacado trabajo en el ámbito científico, que ha sido reconocido con la publicación de sus artículos en revistas de alto impacto.
Este logro refleja el compromiso, la dedicación y la excelencia de nuestros investigadores en la generación de conocimiento que contribuye al desarrollo de la ciencia y la sociedad. Su trabajo no solo fortalece la producción académica de la universidad, sino que también posiciona a nuestra institución en el escenario global de la investigación.
¡Felicitaciones a nuestro investigador y a su equipo por este gran reconocimiento! Seguimos avanzando juntos en el camino de la excelencia académica.